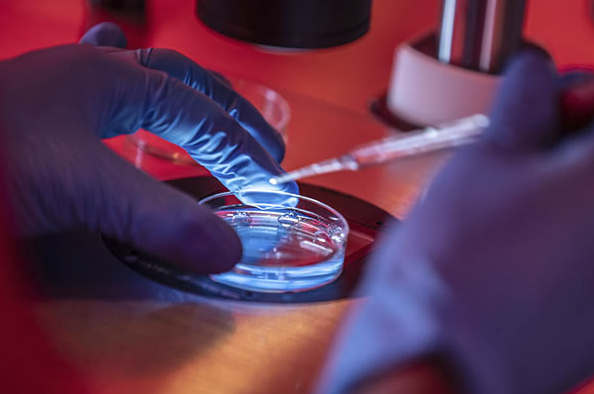

La empresa británica Blossom Keepsake vende joyas que contienen embriones humanos creados mediante fecundación in vitro . La organización provida Live Action ha calificado la práctica de «distópica», mientras que expertos católicos condenan la deshumanización del embrión y la pérdida de respeto por la vida desde su concepción.
La empresa británica Blossom Keepsake ha desatado una fuerte polémica, con muchos católicos reaccionando con indignación ante lo que consideran una grave muestra de desprecio por la vida en su etapa más frágil.
El uso de embriones en joyería no es un fenómeno nuevo.
En 2017, la empresa australiana Baby Bee Hummingbirds generó un debate similar al convertir embriones humanos «excedentes» de tratamientos de fecundación in vitro en collares conmemorativos. En aquel entonces, los bioeticistas advirtieron sobre la «deshumanización del ser humano en la etapa embrionaria».

Según los mitos mesopotámicos y babilónicos, así como fuentes cabalísticas, espiritualistas y astrológicas judías, Lilith fue la primera mujer creada antes que Eva, quien abandonó el Paraíso y encontró su morada en el Infierno. Es la madre de muchos demonios. Lilith es también el demonio del aborto, las enfermedades femeninas y la soberbia.
Fuente: Wikimedia Commons
La Iglesia Católica condena el uso de las técnicas de fertilización in vitro porque implican la manipulación y destrucción de embriones humanos. Millones de ellos, al no ser implantados, fueron desechados, utilizados para experimentación o congelados indefinidamente, lo cual constituye una grave violación de su dignidad.
En su comunicado, Live Action recalcó que los embriones son «considerados propiedad, no seres humanos». Utilizar los restos de un niño asesinado intencionalmente es particularmente satánico. Según Live Action, en Estados Unidos hay más de un millón de embriones humanos congelados. Además, el número de nacimientos resultantes de la fertilización in vitro crece constantemente: en 2023, el 2,6 % de todos los nacimientos en el país fueron producto de estos procedimientos, y esta cifra aumenta cada año.
Con el auge de la industria de la fertilidad, los niños son vistos cada vez menos como seres humanos únicos con derechos innatos y más como productos a los que todo adulto tiene derecho siempre que pueda pagarlos ”, afirmó la organización provida.
El National Catholic Register informó sobre las indignadas reacciones de los católicos en las redes sociales tras la publicación de la noticia. Entre ellos, el bioeticista Aaron Kheriaty comparó el acto con el mundo descrito por Aldous Huxley en su novela Un mundo feliz :
Aquí está nuestro valiente nuevo mundo: un mundo de nihilismo ostentoso y elegante. Embriones humanos envueltos en joyas: un brillante recordatorio de que creamos humanos en un laboratorio y luego los destruimos » ,
escribió Kheriaty en su plataforma X (antes Twitter).
El National Catholic Register también recordó que la instrucción Dignitas personae , publicada en 2008 por la Congregación para la Doctrina de la Fe (ahora Dicasterio para la Doctrina de la Fe), enseña que un embrión humano no puede ser considerado “ mero material de laboratorio ”, porque eso violaría su dignidad intrínseca, “ que pertenece por igual a todos los seres humanos, independientemente de los deseos de sus padres, su condición social, su educación o su desarrollo físico ”.
Si la verdadera fe católica aún habitara en los corazones de los sacerdotes liberales, progresistas y modernistas de la Iglesia Católica, y se centraran no en proteger y bendecir a los sodomitas, sino en proteger a los niños por nacer, sus palabras resonarían con fuerza.
Y si hubiera siquiera un ápice de fe católica en los corazones de quienes consideran el aborto un derecho de la mujer y rechazan la vida desde la concepción, el holocausto de niños por nacer de los siglos XX y XXI jamás habría ocurrido.
Somos testigos de la triste realidad de hasta dónde ha llegado el orgullo de una mente oscurecida y sin fe. Donde antes se adoraba a Dios, ahora los degenerados se regocijan cuando el cadáver de un niño por nacer se convierte en adorno de la vanidad. Quienes se hacen llamar científicos interfieren con la obra de Dios. Y del cuerpo de un niño engendrado al que Dios insufló un alma, ellos, como los últimos paganos ingenuos, fabrican amuletos con sus huesos y su cuerpo. Se creen iguales a Dios, pero no son más que seres miserables que elaboran adornos con los restos de niños asesinados, para su propia vergüenza y la del mundo que representan.
Quien abusa de la inocencia de los no nacidos no lleva un diamante en el pecho, sino una maldición en el corazón. La vida no es una mercancía, y quien mata a un inocente debe temblar, porque la sangre del inocente clama a Dios, como la sangre de Abel. (La frase bíblica «La sangre de Abel clama venganza» significa que la sangre de Abel, asesinado por su hermano Caín, clama justicia y castigo para el perpetrador del crimen, y este castigo le llegará si no se arrepiente de sus pecados).
Por BRANISLAV KRASNOVSKY.
LUNES 10 DE NOVIEMBRE DE 2025.
CHRISTIANITAS.